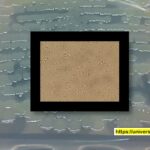
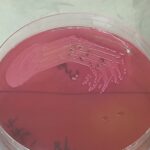

Tag: Pathogen Identification
Citrobacter werkmanii-Introduction, Morphology, Pathogenicity, Lab Diagnosis, Treatment, Prevention, and Keynote
Introduction Citrobacter werkmanii is a gram-negative bacterium commonly found in...
Introduction Citrobacter werkmanii is a gram-negative bacterium commonly found in...
Raoultella ornithinolytica-Introduction, Morphology, Pathogenicity, Lab Diagnosis, Treatment, Prevention, and Keynotes
Introduction Raoultella ornithinolytica, a Gram-negative, encapsulated, non-motile, rod-shaped bacterium, belongs...
Introduction Raoultella ornithinolytica, a Gram-negative, encapsulated, non-motile, rod-shaped bacterium, belongs...
CSF Culture and Sensitivity Test-Introduction, Report, Clinical Significance, Common Pathogens, and Keynotes
 Introduction Cerebrospinal Fluid (CSF) Culture and Sensitivity Test is a...
Introduction Cerebrospinal Fluid (CSF) Culture and Sensitivity Test is a...
